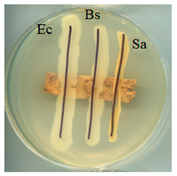
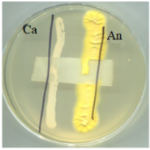
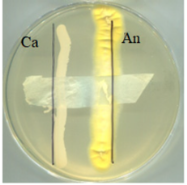
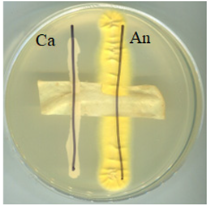
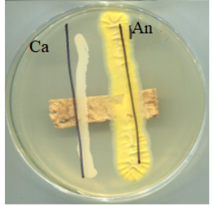

SCOBY Cellulose-Based Materials Hydrophobized Using Stearic Acid and Apple Powder
Abstract
1. Introduction
2. Results and Discussion
2.1. Visual and Sensory Characteristics of Materials
2.2. Morphological Characterisation of the Materials (SEM)
2.3. Structural Analysis (FT-IR)
2.4. Wettability
2.5. Antimicrobial Activity
2.6. Binding Bacterial Cellulose and Pectin—Modelling Interactions
3. Materials and Methods
3.1. Reagents
3.2. Production of Materials
3.2.1. Production of Biopolymer
3.2.2. Bacterial Cellulose Preparation
3.2.3. Bacterial Cellulose Modification with the Apple Powder
3.3. Surface Modifications
3.4. Fourier Transform-Infrared Spectroscopy (FT-IR)
3.5. Surface Wettability
3.6. Scanning Electron Microscopy (SEM)
3.7. Antimicrobial Activity Tests
3.8. Pectin Content Determination
3.9. A Model System of Binding Bacterial Cellulose and Pectin
3.10. Surface Roughness
3.11. Statistical Analysis
4. Conclusions
Author Contributions
Funding
Institutional Review Board Statement
Informed Consent Statement
Data Availability Statement
Conflicts of Interest
References
- Zheng, J.; Suh, S. Strategies to Reduce the Global Carbon Footprint of Plastics. Nat. Clim. Chang. 2019, 9, 374–378. [Google Scholar] [CrossRef]
- Cruz, M.A.; Flor-Unda, O.; Avila, A.; Garcia, M.D.; Cerda-Mejía, L. Advances in Bacterial Cellulose Production: A Scoping Review. Coatings 2024, 14, 1401. [Google Scholar] [CrossRef]
- Jayabalan, R.; Malbaša, R.V.; Lončar, E.S.; Vitas, J.S.; Sathishkumar, M. A Review on Kombucha Tea-Microbiology, Composition, Fermentation, Beneficial Effects, Toxicity, and Tea Fungus. Compr. Rev. Food Sci. Food Saf. 2014, 13, 538–550. [Google Scholar] [CrossRef]
- Esa, F.; Tasirin, S.M.; Rahman, N.A. Overview of Bacterial Cellulose Production and Application. Agric. Agric. Sci. Procedia 2014, 2, 113–119. [Google Scholar] [CrossRef]
- Lahiri, D.; Nag, M.; Dutta, B.; Dey, A.; Sarkar, T.; Pati, S.; Edinur, H.A.; Kari, Z.A.; Noor, N.H.M.; Ray, R.R. Bacterial Cellulose: Production, Characterization, and Application as Antimicrobial Agent. Int. J. Mol. Sci. 2021, 22, 12984. [Google Scholar] [CrossRef]
- Rastogi, A.; Banerjee, R. Statistical Optimization of Bacterial Cellulose Production by Leifsonia Soli and Its Physico-Chemical Characterization. Process Biochem. 2020, 91, 297–302. [Google Scholar] [CrossRef]
- Abitbol, T.; Rivkin, A.; Cao, Y.; Nevo, Y.; Abraham, E.; Ben-Shalom, T.; Lapidot, S.; Shoseyov, O. Nanocellulose, a Tiny Fiber with Huge Applications. Curr. Opin. Biotechnol. 2016, 39, 76–88. [Google Scholar] [CrossRef]
- Campano, C.; Balea, A.; Blanco, A.; Negro, C. Enhancement of the Fermentation Process and Properties of Bacterial Cellulose: A Review. Cellulose 2015, 23, 57–91. [Google Scholar] [CrossRef]
- Wang, Z.; Li, S.; Zhao, X.; Liu, Z.; Shi, R.; Hao, M. Applications of Bacterial Cellulose in the Food Industry and Its Health-Promoting Potential. Food Chem. 2025, 464, 141763. [Google Scholar] [CrossRef]
- Infante-Neta, A.A.; D’Almeida, A.P.; Albuquerque, T.L.D. Bacterial Cellulose in Food Packaging: A Bibliometric Analysis and Review of Sustainable Innovations and Prospects. Processes 2024, 12, 1975. [Google Scholar] [CrossRef]
- Blanco Parte, F.G.; Santoso, S.P.; Chou, C.C.; Verma, V.; Wang, H.T.; Ismadji, S.; Cheng, K.C. Current Progress on the Production, Modification, and Applications of Bacterial Cellulose. Crit. Rev. Biotechnol. 2020, 40, 397–414. [Google Scholar] [CrossRef] [PubMed]
- Rajwade, J.M.; Paknikar, K.M.; Kumbhar, J.V. Applications of Bacterial Cellulose and Its Composites in Biomedicine. Appl. Microbiol. Biotechnol. 2015, 99, 2491–2511. [Google Scholar] [CrossRef] [PubMed]
- Stumpf, T.R.; Yang, X.; Zhang, J.; Cao, X. In Situ and Ex Situ Modifications of Bacterial Cellulose for Applications in Tissue Engineering. Mater. Sci. Eng. C 2018, 82, 372–383. [Google Scholar] [CrossRef]
- Ludwicka, K.; Rytczak, P.; Kołodziejczyk, M.; Gendaszewska-Darmach, E.; Chrzanowski, M.; Kubiak, K.; Jędrzejczak-Krzepkowska, M.; Bielecki, S. Bacterial Nanocellulose—A Biotechnological Product for Biomedical Applications. New Biotechnol. 2016, 33, S17–S18. [Google Scholar] [CrossRef]
- Klemm, D.; Schumann, D.; Udhardt, U.; Marsch, S. Bacterial Synthesized Cellulose—Artificial Blood Vessels for Microsurgery. Prog. Polym. Sci. 2001, 26, 1561–1603. [Google Scholar] [CrossRef]
- Junka, A.; Bartoszewicz, M.; Dziadas, M.; Szymczyk, P.; Dydak, K.; Żywicka, A.; Owczarek, A.; Bil-Lula, I.; Czajkowska, J.; Fijałkowski, K. Application of Bacterial Cellulose Experimental Dressings Saturated with Gentamycin for Management of Bone Biofilm In Vitro and Ex Vivo. J. Biomed. Mater. Res. Part B Appl. Biomater. 2020, 108, 30–37. [Google Scholar] [CrossRef]
- Swingler, S.; Gupta, A.; Heaselgrave, W.; Kowalczuk, M.; Radecka, I. An Investigation into the Anti-Microbial Properties of Bacterial Cellulose Wound Dressings Loaded with Curcumin:Hydroxypropyl-β-Cyclodextrin Supramolecular Inclusion Complex. Access Microbiol. 2019, 1, 19. [Google Scholar] [CrossRef]
- Shao, W.; Wang, S.; Liu, X.; Liu, H.; Wu, J.; Zhang, R.; Min, H.; Huang, M. Tetracycline Hydrochloride Loaded Regenerated Cellulose Composite Membranes with Controlled Release and Efficient Antibacterial Performance. RSC Adv. 2016, 6, 3068–3073. [Google Scholar] [CrossRef]
- de Mattos, I.B.; Nischwitz, S.P.; Tuca, A.C.; Groeber-Becker, F.; Funk, M.; Birngruber, T.; Mautner, S.I.; Kamolz, L.P.; Holzer, J.C.J. Delivery of Antiseptic Solutions by a Bacterial Cellulose Wound Dressing: Uptake, Release and Antibacterial Efficacy of Octenidine and Povidone-Iodine. Burns 2020, 46, 918–927. [Google Scholar] [CrossRef]
- Fijałkowski, K.; Żywicka, A.; Drozd, R.; Junka, A.F.; Peitler, D.; Kordas, M.; Konopacki, M.; Szymczyk, P.; Rakoczy, R. Increased Water Content in Bacterial Cellulose Synthesized under Rotating Magnetic Fields. Electromagn. Biol. Med. 2017, 36, 192–201. [Google Scholar] [CrossRef]
- Paximada, P.; Dimitrakopoulou, E.A.; Tsouko, E.; Koutinas, A.A.; Fasseas, C.; Mandala, I.G. Structural Modification of Bacterial Cellulose Fibrils under Ultrasonic Irradiation. Carbohydr. Polym. 2016, 150, 5–12. [Google Scholar] [CrossRef] [PubMed]
- Wu, C.N.; Fuh, S.C.; Lin, S.P.; Lin, Y.Y.; Chen, H.Y.; Liu, J.M.; Cheng, K.C. TEMPO-Oxidized Bacterial Cellulose Pellicle with Silver Nanoparticles for Wound Dressing. Biomacromolecules 2018, 19, 544–554. [Google Scholar] [CrossRef] [PubMed]
- Fernandes, S.C.M.; Sadocco, P.; Alonso-Varona, A.; Palomares, T.; Eceiza, A.; Silvestre, A.J.D.; Mondragon, I.; Freire, C.S.R. Bioinspired Antimicrobial and Biocompatible Bacterial Cellulose Membranes Obtained by Surface Functionalization with Aminoalkyl Groups. ACS Appl. Mater. Interfaces 2013, 5, 3290–3297. [Google Scholar] [CrossRef] [PubMed]
- Ávila Ramírez, J.A.; Gómez Hoyos, C.; Arroyo, S.; Cerrutti, P.; Foresti, M.L. Acetylation of Bacterial Cellulose Catalyzed by Citric Acid: Use of Reaction Conditions for Tailoring the Esterification Extent. Carbohydr. Polym. 2016, 153, 686–695. [Google Scholar] [CrossRef]
- Lopes, T.D.; Riegel-Vidotti, I.C.; Grein, A.; Tischer, C.A.; de Sousa Faria-Tischer, P.C. Bacterial Cellulose and Hyaluronic Acid Hybrid Membranes: Production and Characterization. Int. J. Biol. Macromol. 2014, 67, 401–408. [Google Scholar] [CrossRef]
- Dehnad, D.; Mirzaei, H.; Emam-Djomeh, Z.; Jafari, S.M.; Dadashi, S. Thermal and Antimicrobial Properties of Chitosan–Nanocellulose Films for Extending Shelf Life of Ground Meat. Carbohydr. Polym. 2014, 109, 148–154. [Google Scholar] [CrossRef]
- Indriyati; Frecilla, N.; Nuryadin, B.W.; Irmawati, Y.; Srikandace, Y. Enhanced Hydrophobicity and Elasticity of Bacterial Cellulose Films by Addition of Beeswax. Macromol. Symp. 2020, 391, 1900174. [Google Scholar] [CrossRef]
- Sommer, A.; Staroszczyk, H.; Sinkiewicz, I.; Bruździak, P. Preparation and Characterization of Films Based on Disintegrated Bacterial Cellulose and Montmorillonite. J. Polym. Environ. 2021, 29, 1526–1541. [Google Scholar] [CrossRef]
- Ellis, J.D.; Graham, J.R.; Mortensen, A. Standard Methods for Wax Moth Research. J. Apic. Res. 2013, 52, 1–17. [Google Scholar] [CrossRef]
- Wen, X.; Zheng, Y.; Wu, J.; Yue, L.; Wang, C.; Luan, J.; Wu, Z.; Wang, K. In Vitro and In Vivo Investigation of Bacterial Cellulose Dressing Containing Uniform Silver Sulfadiazine Nanoparticles for Burn Wound Healing. Prog. Nat. Sci. Mater. Int. 2015, 25, 197–203. [Google Scholar] [CrossRef]
- Bryszewska, M.A.; Tabandeh, E.; Jędrasik, J.; Czarnecka, M.; Dzierżanowska, J.; Ludwicka, K. SCOBY Cellulose Modified with Apple Powder—Biomaterial with Functional Characteristics. Int. J. Mol. Sci. 2023, 24, 1005. [Google Scholar] [CrossRef] [PubMed]
- Cichosz, S.; Masek, A. IR Study on Cellulose with the Varied Moisture Contents: Insight into the Supramolecular Structure. Materials 2020, 13, 4573. [Google Scholar] [CrossRef] [PubMed]
- Ciolacu, D.; Chiriac, A.I.; Pastor, F.I.J.; Kokol, V. The Influence of Supramolecular Structure of Cellulose Allomorphs on the Interactions with Cellulose-Binding Domain, CBD3b from Paenibacillus Barcinonensis. Bioresour. Technol. 2014, 157, 14–21. [Google Scholar] [CrossRef] [PubMed]
- Agustin, S.; Wahyuni, E.T.; Suparmo, S.; Supriyadi, S.; Cahyanto, M.N. Incorporation of Pectin during Biosynthesis of Bacterial Cellulose by Gluconacetobacter Xylinus InaCC B404: Possibility for Producing Green Food Packaging. Biodiversitas J. Biol. Divers. 2021, 22, 2548–2553. [Google Scholar] [CrossRef]
- Kumar, R.; Singh, A.; Garg, N.; Siril, P.F. Solid Lipid Nanoparticles for the Controlled Delivery of Poorly Water Soluble Non-Steroidal Anti-Inflammatory Drugs. Ultrason. Sonochem. 2018, 40, 686–696. [Google Scholar] [CrossRef]
- Kimura, F.; Umemura, J.; Takenaka, T. FTIR–ATR Studies on Langmuir–Blodgett Films of Stearic Acid with 1–9 Monolayers. Langmuir 1986, 2, 96–101. [Google Scholar] [CrossRef]
- Huang, C.; Yang, X.Y.; Xiong, L.; Guo, H.J.; Luo, J.; Wang, B.; Zhang, H.R.; Lin, X.Q.; Chen, X.D. Evaluating the Possibility of Using Acetone-butanol-ethanol (ABE) Fermentation Wastewater for Bacterial Cellulose Production by Gluconacetobacter Xylinus. Lett. Appl. Microbiol. 2015, 60, 491–496. [Google Scholar] [CrossRef]
- Sun, D.; Yang, J.; Wang, X. Bacterial Cellulose/TiO2 Hybrid Nanofibers Prepared by the Surface Hydrolysis Method with Molecular Precision. Nanoscale 2010, 2, 287–292. [Google Scholar] [CrossRef]
- Dayal, M.S.; Goswami, N.; Sahai, A.; Jain, V.; Mathur, G.; Mathur, A. Effect of Media Components on Cell Growth and Bacterial Cellulose Production from Acetobacter Aceti MTCC 2623. Carbohydr. Polym. 2013, 94, 12–16. [Google Scholar] [CrossRef]
- Yassine, F.; Bassil, N.; Chokr, A.; El Samrani, A.; Serghei, A.; Boiteux, G.; El Tahchi, M. Two-Step Formation Mechanism of Acetobacter Cellulosic Biofilm: Synthesis of Sparse and Compact Cellulose. Cellulose 2016, 23, 1087–1100. [Google Scholar] [CrossRef]
- Castro, C.; Vesterinen, A.; Zuluaga, R.; Caro, G.; Filpponen, I.; Rojas, O.J.; Kortaberria, G.; Gañán, P. In Situ Production of Nanocomposites of Poly (Vinyl Alcohol) and Cellulose Nanofibrils from Gluconacetobacter Bacteria: Effect of Chemical Crosslinking. Cellulose 2014, 21, 1745–1756. [Google Scholar] [CrossRef]
- Kim, H.; Song, J.E.; Kim, H.R. Comparative Study on the Physical Entrapment of Soy and Mushroom Proteins on the Durability of Bacterial Cellulose Bio-leather. Cellulose 2021, 28, 3183–3200. [Google Scholar] [CrossRef]
- Provin, A.P.; dos Reis, V.O.; Hilesheim, S.E.; Bianchet, R.T.; de Aguiar Dutra, A.R.; Cubas, A.L.V. Use of Bacterial Cellulose in the Textile Industry and the Wettability Challenge—A Review. Cellulose 2021, 28, 8255–8274. [Google Scholar] [CrossRef]
- Ahadian, S.; Mohseni, M.; Moradian, S. Ranking Proposed Models for Attaining Surface Free Energy of Powders Using Contact Angle Measurements. Int. J. Adhes. Adhes. 2009, 29, 458–469. [Google Scholar] [CrossRef]
- Rouhi, M.; Garavand, F.; Heydari, M.; Mohammadi, R.; Sarlak, Z.; Cacciotti, I.; Razavi, S.H.; Mousavi, M.; Parandi, E. Fabrication of Novel Antimicrobial Nanocomposite Films Based on Polyvinyl Alcohol, Bacterial Cellulose Nanocrystals, and Boric Acid for Food Packaging. J. Food Meas. Charact. 2024, 18, 2146–2161. [Google Scholar] [CrossRef]
- Desbois, A.P. Potential Applications of Antimicrobial Fatty Acids in Medicine, Agriculture and Other Industries. Recent Pat. Anti Infect. Drug Discov. 2012, 7, 111–122. [Google Scholar] [CrossRef]
- Kumar, P.; Lee, J.H.; Beyenal, H.; Lee, J. Fatty Acids as Antibiofilm and Antivirulence Agents. Trends Microbiol. 2020, 28, 753–768. [Google Scholar] [CrossRef]
- Vandorou, M.; Plakidis, C.; Tsompanidou, I.M.; Adamantidi, T.; Panagopoulou, E.A.; Tsoupras, A. A Review on Apple Pomace Bioactives for Natural Functional Food and Cosmetic Products with Therapeutic Health-Promoting Properties. Int. J. Mol. Sci. 2024, 25, 10856. [Google Scholar] [CrossRef]
- Lyu, F.; Luiz, S.F.; Azeredo, D.R.P.; Cruz, A.G.; Ajlouni, S.; Ranadheera, C.S. Apple Pomace as a Functional and Healthy Ingredient in Food Products: A Review. Processes 2020, 8, 319. [Google Scholar] [CrossRef]
- Bonnin, E.; Garnier, C.; Ralet, M.C. Pectin-Modifying Enzymes and Pectin-Derived Materials: Applications and Impacts. Appl. Microbiol. Biotechnol. 2014, 98, 519–532. [Google Scholar] [CrossRef]
- Nishiyama, Y. Molecular Interactions in Nanocellulose Assembly. Philos. Trans. R. Soc. A Math. Phys. Eng. Sci. 2018, 376, 20170047. [Google Scholar] [CrossRef] [PubMed]
- Chen, P.; Nishiyama, Y.; Mazeau, K. Atomic Partial Charges and One Lennard-Jones Parameter Crucial to Model Cellulose Allomorphs. Cellulose 2014, 21, 2207–2217. [Google Scholar] [CrossRef]
- Loerbroks, C.; Rinaldi, R.; Thiel, W. The Electronic Nature of the 1,4-β-Glycosidic Bond and Its Chemical Environment: DFT Insights into Cellulose Chemistry. Chem. A Eur. J. 2013, 19, 16282–16294. [Google Scholar] [CrossRef] [PubMed]
- Cardamone, S.; Popelier, P.L.A. Prediction of Conformationally Dependent Atomic Multipole Moments in Carbohydrates. J. Comput. Chem. 2015, 36, 2361–2373. [Google Scholar] [CrossRef]
- Wohlert, M.; Benselfelt, T.; Wågberg, L.; Furó, I.; Berglund, L.A.; Wohlert, J. Cellulose and the Role of Hydrogen Bonds: Not in Charge of Everything. Cellulose 2022, 29, 1–23. [Google Scholar] [CrossRef]
- Jarvis, M.C. Hydrogen Bonding and Other Non-Covalent Interactions at the Surfaces of Cellulose Microfibrils. Cellulose 2022, 30, 667–687. [Google Scholar] [CrossRef]
- Igarashi, T.; Hoshi, M.; Nakamura, K.; Kaharu, T.; Murata, K.I. Direct Observation of Bound Water on Cotton Surfaces by Atomic Force Microscopy and Atomic Force Microscopy-Infrared Spectroscopy. J. Phys. Chem. C 2020, 124, 4196–4201. [Google Scholar] [CrossRef]
- Salmén, L.; Stevanic, J.S.; Holmqvist, C.; Yu, S. Moisture Induced Straining of the Cellulosic Microfibril. Cellulose 2021, 28, 3347–3357. [Google Scholar] [CrossRef]
- Żenkiewicz, M. Adhezja i Modyfikowanie Warstwy Wierzchniej Tworzyw Wielkocząsteczkowych; Wydawnictwa Naukowo-Techniczne: Warsaw, Poland, 2000; ISBN 8320425476. [Google Scholar]
- Rudawska, A.; Jacniacka, E. Analysis for Determining Surface Free Energy Uncertainty by the Owen-Wendt Method. Int. J. Adhes. Adhes. 2009, 29, 451–457. [Google Scholar] [CrossRef]
- Chandel, V.; Vaidya, D.; Kaushal, M.; Gupta, A.; Verma, A. Standardization of Eco-Friendly Technique for Extraction of Pectin from Apple Pomace. Indian J. Nat. Prod. Resour. 2016, 7, 69–73. [Google Scholar]
- EN ISO 4288:1997; Geometrical Product Specifications (GPS)-Surface Texture: Profile Method-Rules and Procedures for the Assessment of Surface Texture (ISO 4288:1996). 1997. Available online: https://standards.iteh.ai/catalog/standards/cen/234bef88-8bd6-42c1-9fda-5b2589f280d4/en-iso-4288-1997?srsltid=AfmBOoqaVzeVIE2KRXdP2lgww1qwTCt4mA6oUtAbK5UzUBmEfRwhFiRs (accessed on 28 October 2022).
- R: The R Project for Statistical Computing. Available online: https://www.r-project.org/ (accessed on 28 October 2022).
- CRAN—Package Agricolae. Available online: https://cran.r-project.org/web/packages/agricolae/index.html (accessed on 28 October 2022).





| Material | Sensory Characteristics | ||
|---|---|---|---|
| Colour Uniformity | Tactile Sensation | Flexibility and Fracture Resilience | |
| BC | Darker, patchy discolouration, semitransparent | Smooth, dry | Flexible |
| A0 | Uniform, semitransparent | Smooth, slightly oily | Flexible |
| A0[S1], A0[S3], A0[S5], A0[S10], | Uniform, opaque | Dry, nonslip feel upon touch | Crumbling and cracking |
| A40 | Areas of discolouration, opaque | Smooth, slightly slippery but pleasant to the touch | Flexible |
| A40[S1], A40[S3], A40[S5], A40[S10] | Uniform, opaque | Dry, rough | Cracking when bent |
| A0[S1.A60], A0[S10.A60] | Areas of discolouration, opaque | Slightly slippery, smooth | Flexible |
| A40[S1.A60], A40[S10.A60] | Darker, patchy discolouration, opaque | Dry, rough, perceptible unevenness | Flexible, susceptible to cracking |
| Material | ||||
|---|---|---|---|---|
| BC | A0 | A40 | A0[S10.A60] | |
| Water contact angle [°] | 38.0 ± 3.4 c | 44.0 ± 7.5 c | 83.1 ± 5.0 b | 124.5 ± 2.4 a |
![]() | ![]() | ![]() | ![]() | |
| Diiodomethane contact angle [°] | 69.9 ± 2.0 b | 74.3 ± 8.5 b | 76.0 ± 2.2 b | 101.1 ± 3.7 a |
![]() | ![]() | ![]() | ![]() | |
| Polar component [mJ/m2] | 47.5 ± 1.3 | 44.7 ± 1.7 | 10.3 ± 1.9 | 0.1 ± 0.9 |
| Dispersive component [mJ/m2] | 11.6 ± 0.7 | 10.1 ± 1.7 | 14.7 ± 0.8 | 8.3 ± 1.4 |
| Surface Free Energy [mJ/m2] | 59.2 ± 0.9 a | 52.7 ± 1.7 b | 25.0 ± 1.4 c | 8.4 ± 1.2 d |
| Roughness | ||||
| Ra [µm] | 0.3 ± 0.0 b | 4.6 ± 1.7 a | 4.6. ± 0.9 a | 1.2 ± 0.2 b |
| Rmax [µm] | 2.3 ± 0.2 b | 37.7 ± 11.5 a | 32.1 ± 8.3 a | 8.5 ± 1.7 b |
| Rz [µm] | 1.8 ± 0.2 b | 21.9 ± 7.6 a | 21.7 ± 6.9 a | 6.4 ± 1.4 b |
| Material | ||||
|---|---|---|---|---|
| Strain | BC | A0 | A40 | A0[S10A60] |
![]() | ![]() | ![]() | ![]() | |
![]() | ![]() | ![]() | ![]() | |
| E. coli (Ec) | - | - | - | - |
| S. aureus (Sa) | - | - | - | - |
| B. subtilis (Bs) | - | - | - | - |
| C. albicans (Ca) | - | + | + | - |
| A. niger (An) | - | + | + | - |
| Compound | Chemical Composition | Energy, E [kcal/mol] | Number of Hydrogen Bonds | ||
|---|---|---|---|---|---|
| C | O | H | |||
| Cellulose | 80 | 92 | 152 | −4338 | 48 |
| Homogalakturonan | 35 | 30 | 56 | −1364 | 4 |
| Ramnogalakturonan | 75 | 62 | 126 | −2804 | 12 |
| Cellulose with Homogalakturonan | 115 | 122 | 208 | −5710 | 97 |
| Cellulose with Ramnogalakturonan | 155 | 154 | 278 | −7158 | 82 |
| Material Code | Sample Composition | ||||
|---|---|---|---|---|---|
| Core | Coating | ||||
| Glycerol [%] | Apple Powder [%] | Stearic Acid [%] | Apple Powder [%] | ||
| 1 | BC | 0 | 0 | 0 | 0 |
| 2 | A0 | 30 | 0 | 0 | 0 |
| 3 | A0[S1] | 30 | 0 | 1 | 0 |
| 4 | A0[S3] | 30 | 0 | 3 | 0 |
| 5 | A0[S5] | 30 | 0 | 5 | 0 |
| 6 | A0[S10] | 30 | 0 | 10 | 0 |
| 7 | A40 | 30 | 40 | 0 | 0 |
| 8 | A40[S1] | 30 | 40 | 1 | 0 |
| 9 | A40[S3] | 30 | 40 | 3 | 0 |
| 10 | A40[S5] | 30 | 40 | 5 | 0 |
| 11 | A40[S10] | 30 | 40 | 10 | 0 |
| 12 | A0[S1.A60] | 30 | 0 | 1 | 60 |
| 13 | A0[S10.A60] | 30 | 0 | 10 | 60 |
| 14 | A40[S1.A60] | 30 | 40 | 1 | 60 |
| 15 | A40[S10.A60] | 30 | 40 | 10 | 60 |
| Growth Inhibition Zone [mm] | Growth Characteristics | IMPACT | |
|---|---|---|---|
| >1 | Inhibition of growth around and under the sample. | Very good activity | +++ |
| 0–1 | Inhibition of growth around and under the sample. | Good activity | ++ |
| 0 | The sample did not produce a zone of inhibition and did not inhibit growth. | ||
| 0 | No zone of growth inhibition, slight growth under the sample. | Low activity | + |
| 0 | There was no zone of growth. inhibition observed, but growth was detected under the sample. | Lack of activity | - |
Disclaimer/Publisher’s Note: The statements, opinions and data contained in all publications are solely those of the individual author(s) and contributor(s) and not of MDPI and/or the editor(s). MDPI and/or the editor(s) disclaim responsibility for any injury to people or property resulting from any ideas, methods, instructions or products referred to in the content. |
© 2024 by the authors. Licensee MDPI, Basel, Switzerland. This article is an open access article distributed under the terms and conditions of the Creative Commons Attribution (CC BY) license (https://creativecommons.org/licenses/by/4.0/).
Share and Cite
Bryszewska, M.A.; Pareja, D.G.; Kaczmarek, L.; Sobczyk-Guzenda, A.; Piotrowska, M.; Batory, D. SCOBY Cellulose-Based Materials Hydrophobized Using Stearic Acid and Apple Powder. Int. J. Mol. Sci. 2024, 25, 13746. https://doi.org/10.3390/ijms252413746
Bryszewska MA, Pareja DG, Kaczmarek L, Sobczyk-Guzenda A, Piotrowska M, Batory D. SCOBY Cellulose-Based Materials Hydrophobized Using Stearic Acid and Apple Powder. International Journal of Molecular Sciences. 2024; 25(24):13746. https://doi.org/10.3390/ijms252413746
Chicago/Turabian StyleBryszewska, Malgorzata Anita, Daniel Gutierez Pareja, Lukasz Kaczmarek, Anna Sobczyk-Guzenda, Malgorzata Piotrowska, and Damian Batory. 2024. "SCOBY Cellulose-Based Materials Hydrophobized Using Stearic Acid and Apple Powder" International Journal of Molecular Sciences 25, no. 24: 13746. https://doi.org/10.3390/ijms252413746
APA StyleBryszewska, M. A., Pareja, D. G., Kaczmarek, L., Sobczyk-Guzenda, A., Piotrowska, M., & Batory, D. (2024). SCOBY Cellulose-Based Materials Hydrophobized Using Stearic Acid and Apple Powder. International Journal of Molecular Sciences, 25(24), 13746. https://doi.org/10.3390/ijms252413746